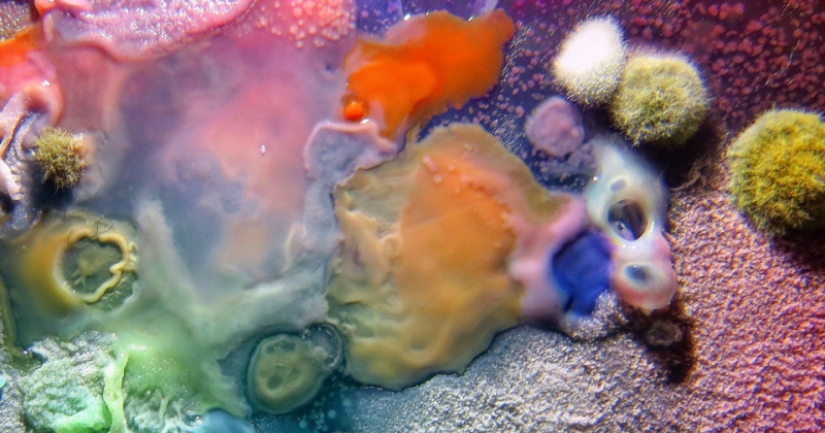
La niña mostró claramente el peligro bacteriano de los iconos de la iglesia

La niña mostró claramente el peligro bacteriano de los iconos de la iglesia
Categorias: Ciencias
Por Pictolic https://www.pictolic.com/es/article/la-nina-mostr-claramente-el-peligro-bacteriano-de-los-iconos-de-la-iglesia.htmlDaria Fedorova es creyente y, como es costumbre entre los ortodoxos, toca iconos en las iglesias. Pero, como persona moderna, la niña quería saber exactamente qué vive en la superficie de los santuarios. Hizo diez descargas de imágenes en seis iglesias de Moscú y realizó un análisis bacteriológico de estas muestras.

Se debe decir de inmediato que Daria no hacer un descubrimiento en microbiología. La niña está estudiando en la Escuela Británica de Diseño y esto es solo parte de su gran trabajo llamado "El Viaje del Bioma Humano". Quería considerar los iconos no como objetos religiosos, sino como un hogar para muchos microorganismos diferentes.
El proyecto de larga data de Fedorova ha ganado un segundo significado recientemente, en el contexto de los eventos recientes con la epidemia de coronavirus. Durante los ritos ortodoxos, los creyentes entran en contacto directo con objetos que muchas otras personas han tocado antes. Los microorganismos que viven en iconos pueden representar un peligro mortal para los feligreses, a pesar de su creencia en la protección divina.
Daria, junto con un empleado del laboratorio biológico, visitó templos e hizo rubores con iconos. No pidió permiso a los sacerdotes y no informó a los guardias, pero lo hizo inadvertido, en secreto. Fedorova ni siquiera dudó de que habría muchas cosas interesantes en las imágenes, porque en el vidrio de uno de los santuarios, los rastros de brillo de labios eran visibles incluso a simple vista.
Lo que no está en los iconos ortodoxos de Moscú
En los viejos tiempos, cuando comenzaron las epidemias, las iglesias se cerraban, porque la gente adivinaba que los iconos podían ser portadores de infecciones en la Edad Media. Además de los objetos sagrados, el vino de iglesia también puede contener bacterias peligrosas.

Las bacterias de los iconos se ven hermosas e intimidantes
En la comunión, cuando hay 20-30 personas en la cola, los que están al final de la cola ya no beben cahors, sino la saliva de los creyentes anteriores. Al final, necesitas besar la mano del padre, con lo que a Daria tampoco le importaría hacer un análisis.
Daria y su compañera hicieron rubores en seis templos ubicados en Zamoskvorechye. Se examinaron los iconos de San Sergio, la Resurrección de Cristo, los Serafines de Sarov, Santa Isabel, la Madre de Dios, el Bautismo del Señor, Spyridon de Trimifunt, el "Cáliz Inagotable".

Resultó que estafilococos, Estreptococos, Pseudomonas aeruginosa y E. coli coexisten perfectamente en las gafas y los salarios de los iconos. También había bacterias sospechosamente similares al ántrax. Afortunadamente, resultó ser solo microorganismos relacionados y no peligrosos.Afortunadamente, todas las bacterias de los iconos eran desagradables, pero no mortales. A pesar de esto, Daria todavía recomienda que antes de besar el icono, limpie cuidadosamente el vidrio con un paño desinfectante. Desafortunadamente, muchos creyentes, y no solo cristianos, creen que la fe es más fuerte que los virus. Por ejemplo, este hombre de Irán, lamiendo la valla de una mezquita chiíta, está seguro de su seguridad.
Palabras clave: Bacterias | Enfermedad | Icono | Moscú | Peligro | Ortodoxia | Iglesia
Publicar artículo de noticiasArtículos Recientes
Ya es hora de admitir que toda esta idea hipster ha ido demasiado lejos. El concepto se ha vuelto tan popular que incluso los ...
Hay una percepción de que las personas sólo utilizan el 10% de su cerebro potencial. Pero los héroes de nuestra revisión, al ...
Artículos relacionados
Acercarse no sólo a la época de las vacaciones y la diversión, sino también el tiempo de la gripe. Cada año, el número de ...
Lauren Wasser (Lauren Wasser) una vez vivió una vida ordinaria. Trabajaba como modelo, jugaba baloncesto en su tiempo libre, a ...
Creemos que una nutrición adecuada para los resfriados es una bebida caliente abundante, caldo de pollo y fruta. Pero los médicos ...

Año Nuevo es una época para sorprender y deleitar a los seres queridos, no solo con regalos, sino también con una presentación ...